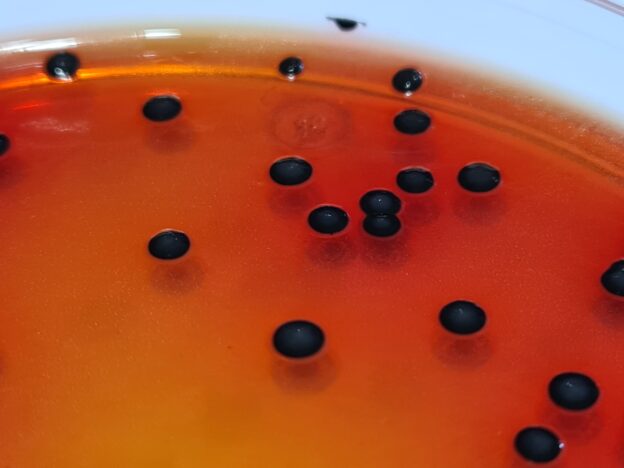

SALMONELLA-SHIGELLA AGAR (SS Agar) – Medio Selectivo para el Aislamiento de Salmonella y Shigella
El Salmonella-Shigella Agar (SS Agar) es un medio de cultivo sólido selectivo y diferencial empleado para el aislamiento de colonias de Salmonella y Shigella en alimentos, aguas y muestras clínicas.
Desarrollado según las normas APHA y UNE-EN ISO 6579:2003, este medio permite una identificación precisa de los microorganismos entéricos patógenos, distinguiéndolos de otras bacterias de la flora acompañante.
Composición del Medio (por litro)
- Peptona pancreática de carne: 5,00 g
- Extracto de carne: 5,00 g
- Sales biliares: 8,50 g
- Citrato sódico: 10,00 g
- Tiosulfato sódico: 8,50 g
- Citrato férrico amoniacal: 1,00 g
- Lactosa: 10,00 g
- Rojo neutro: 25 mg
- Verde brillante: 0,33 mg
- Agar-agar: 15,00 g
Apariencia del medio con E. coli, Salmonella y Shigella: Colonias diferenciadas según su capacidad fermentadora y producción de H₂S.
⚗️ Preparación
- Disolver 63 g de medio deshidratado en 1 litro de agua destilada.
- Calentar con agitación hasta ebullición para su completa disolución.
- Mantener la ebullición durante 2 minutos.
- Autoclavar a 116 ºC durante 5 minutos.
- El color final del medio debe ser rojo-naranja.
Uso exclusivo en laboratorio.
Mantener el envase bien cerrado, en lugar seco, fresco y oscuro.
Agitar antes de usar.
⚠️ Precaución: contiene sales biliares.
Código deshidratado: DMT107
Control de Calidad del Medio
El control de calidad se realiza en nuestros laboratorios siguiendo la norma ISO/TS 11133-2 (métodos ISO 6579 e ISO 12824). Se recomienda repetirlo localmente cuando:
- El medio lleva más de 3 meses sin uso.
- El laboratorio ha sido recientemente desinfectado.
- Se ha almacenado a altas temperaturas.
- Presenta alteraciones visuales aunque no haya caducado.
Aspecto del medio:
- Deshidratado: Polvo fino, color rosáceo.
- Preparado: Medio estéril, color rojo-naranja.
Evaluación del Rendimiento (24–48 h, 37 ºC)
| Microorganismo | Resultado esperado | Observaciones |
|---|---|---|
| Salmonella abony MKTN 6017 | Colonias incoloras con centro negro | Productividad >50–96% respecto a TSA |
| Shigella flexneri MKTA 12022 | Colonias incoloras | Buen crecimiento |
| E. coli MKTA 25922 | Inhibición parcial o total | Puede crecer a las 48 h |
| Enterococcus faecalis MKTN 775 | Inhibición completa | Ninguna colonia visible |
| Proteus mirabilis MKTA 14153 | Colonias incoloras |
https://www.microkit.es/fichas/SALMONELLA-SHIGELLA-AGAR.pdf
Si desea más información y precios actualizados sobre nuestro SALMONELLA-SHIGELLA AGAR (SS AGAR), póngase en contacto con nosotros a través de nuestro correo electrónico microkit@microkit.es o por teléfono en el nº 91-897 46 16
Ver tambien SS Broth, mucho mejor caldo de enriquecimiento selectivo que el Rappaport, Tetrationato o Selenito:
https://www.microkit.es/fichas/SALMONELLA-SHIGELLA-MICROKIT-BROTH.pdf
https://www.microkit.es/fichas/SALMONELLA-SHIGELLA-AGAR.pdf
https://www.microkit.es/monograficos/5-Salmonella-y-Shigella-monograf–a.pdf